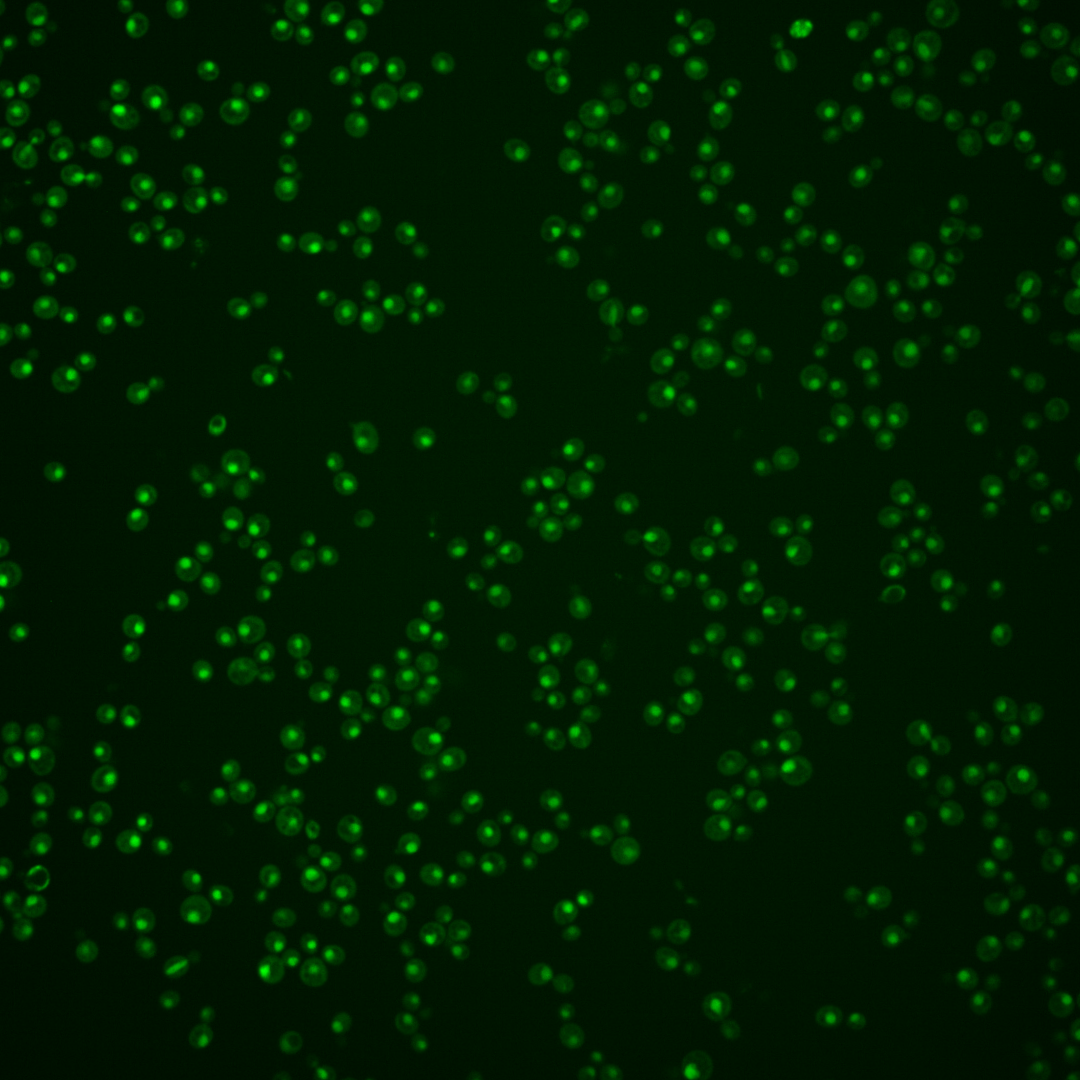

| Standard name | |
|---|---|
| Human Ortholog | |
| Description | Ubiquitin-conjugating enzyme (E2); involved in postreplication repair as a heterodimer with Rad18p, regulation of K63 polyubiquitination in response to oxidative stress, DSBR and checkpoint control as a heterodimer with Bre1p, ubiquitin-mediated N-end rule protein degradation as a heterodimer with Ubr1p, ERAD with Ubr1p in the absence of canonical ER membrane ligases, and Rpn4p turnover as part of proteasome homeostasis, in complex with Ubr2p and Mub1p |
Micrographs




















































































Sub-cellular Localization
Yeast GFP Assignment
Protein Abundance
Localization Change
External localization resources
| ensLOC | DeepLoc | |||||||||||||||||||||||
|---|---|---|---|---|---|---|---|---|---|---|---|---|---|---|---|---|---|---|---|---|---|---|---|---|
| Localization | WT1 | WT2 | WT3 | RAP60 | RAP140 | RAP220 | RAP300 | RAP380 | RAP460 | RAP540 | RAP620 | RAP700 | HU80 | HU120 | HU160 | rpd3Δ_1 | rpd3Δ_2 | rpd3Δ_3 | WT1 | WT2 | WT3 | AF100 | AF140 | AF180 |
| Cortical Patches | 0 | 0 | 0 | 0 | 0 | 0 | 0 | – | 0 | 0 | 0 | 0 | 0 | 0 | 1 | 0 | 0 | 0 | 0 | 0 | 0 | 1 | 0 | 0 |
| Bud | 0 | 0 | 0 | 0 | 0 | 0 | 2 | – | 0 | 2 | 2 | 2 | 0 | 0 | 0 | 0 | 0 | 0 | 3 | 0 | 1 | 2 | 4 | 3 |
| Bud Neck | 0 | 0 | 0 | 0 | 0 | 0 | 0 | – | 0 | 0 | 0 | 1 | 0 | 0 | 0 | 0 | 0 | 0 | 0 | 0 | 0 | 0 | 0 | 0 |
| Bud Site | 0 | 0 | 0 | 0 | 0 | 1 | 0 | – | 1 | 2 | 6 | 4 | 0 | 0 | 0 | 0 | 0 | 0 | – | – | – | – | – | – |
| Cell Periphery | 0 | 0 | 0 | 0 | 0 | 0 | 0 | – | 0 | 0 | 0 | 0 | 0 | 0 | 0 | 0 | 0 | 1 | 0 | 0 | 0 | 0 | 0 | 0 |
| Cytoplasm | 5 | 3 | 6 | 9 | 19 | 20 | 32 | – | 21 | 11 | 26 | 22 | 5 | 35 | 53 | 10 | 9 | 23 | 0 | 0 | 0 | 1 | 0 | 1 |
| Endoplasmic Reticulum | 0 | 0 | 0 | 0 | 0 | 0 | 0 | – | 0 | 0 | 1 | 0 | 0 | 0 | 0 | 5 | 6 | 6 | 0 | 0 | 0 | 0 | 0 | 0 |
| Endosome | 0 | 0 | 0 | 1 | 1 | 0 | 1 | – | 4 | 6 | 9 | 12 | 1 | 0 | 2 | 0 | 8 | 1 | 1 | 1 | 1 | 0 | 1 | 1 |
| Golgi | 0 | 0 | 1 | 0 | 8 | 0 | 22 | – | 1 | 9 | 1 | 0 | 0 | 4 | 2 | 24 | 29 | 21 | 1 | 0 | 0 | 0 | 1 | 2 |
| Mitochondria | 0 | 1 | 0 | 1 | 0 | 25 | 5 | – | 27 | 21 | 50 | 42 | 0 | 0 | 0 | 1 | 1 | 1 | 0 | 0 | 2 | 0 | 0 | 0 |
| Nucleus | 152 | 81 | 119 | 231 | 253 | 199 | 362 | – | 248 | 237 | 274 | 313 | 214 | 271 | 201 | 160 | 155 | 141 | 177 | 97 | 122 | 145 | 265 | 193 |
| Nuclear Periphery | 0 | 0 | 0 | 1 | 1 | 1 | 1 | – | 4 | 0 | 1 | 2 | 0 | 0 | 0 | 1 | 0 | 0 | 0 | 0 | 0 | 0 | 1 | 0 |
| Nucleolus | 27 | 10 | 4 | 5 | 5 | 23 | 13 | – | 23 | 32 | 58 | 65 | 16 | 8 | 14 | 6 | 3 | 9 | 9 | 3 | 4 | 9 | 37 | 31 |
| Peroxisomes | 0 | 0 | 0 | 0 | 0 | 0 | 0 | – | 0 | 1 | 0 | 0 | 0 | 0 | 3 | 1 | 0 | 0 | 0 | 0 | 0 | 0 | 0 | 0 |
| SpindlePole | 0 | 0 | 0 | 1 | 0 | 1 | 3 | – | 1 | 0 | 0 | 1 | 0 | 0 | 2 | 0 | 2 | 0 | 0 | 0 | 0 | 0 | 1 | 3 |
| Vac/Vac Membrane | 10 | 4 | 6 | 9 | 44 | 41 | 72 | – | 41 | 46 | 61 | 76 | 10 | 23 | 33 | 59 | 65 | 103 | 3 | 2 | 3 | 7 | 27 | 52 |
| Unique Cell Count | 182 | 89 | 131 | 251 | 322 | 280 | 477 | 331 | 336 | 427 | 476 | 239 | 335 | 299 | 243 | 245 | 275 | 201 | 107 | 137 | 171 | 343 | 291 | |
| Labelled Cell Count | 194 | 99 | 136 | 258 | 331 | 311 | 513 | 371 | 367 | 489 | 540 | 246 | 341 | 311 | 267 | 278 | 306 | 201 | 107 | 137 | 171 | 343 | 291 | |
Yeast GFP Assignment
Protein Abundance
| Screen | WT1 | WT2 | WT3 | RAP60 | RAP140 | RAP220 | RAP300 | RAP380 | RAP460 | RAP540 | RAP620 | RAP700 | HU80 | HU120 | HU160 | rpd3Δ_1 | rpd3Δ_2 | rpd3Δ_3 | AF100 | AF140 | AF180 |
|---|---|---|---|---|---|---|---|---|---|---|---|---|---|---|---|---|---|---|---|---|---|
| Mean Cell GFP Intensity (1e-4) | 15.2 | 17.5 | 13.8 | 14.5 | 17.1 | 10.0 | 14.6 | – | 12.3 | 12.7 | 11.4 | 11.7 | 19.3 | 18.6 | 19.2 | 28.3 | 26.8 | 26.5 | 14.2 | 15.7 | 15.5 |
| Std Deviation (1e-4) | 6.2 | 8.3 | 5.2 | 5.4 | 6.1 | 4.4 | 6.4 | – | 5.4 | 5.2 | 4.9 | 5.0 | 6.7 | 7.5 | 7.8 | 8.9 | 8.7 | 8.9 | 6.2 | 7.0 | 7.5 |
| Intensity Change (Log2) | – | – | – | 0.08 | 0.32 | -0.46 | 0.09 | – | -0.16 | -0.12 | -0.27 | -0.24 | 0.49 | 0.43 | 0.48 | 1.04 | 0.96 | 0.95 | 0.04 | 0.19 | 0.17 |
Localization Change
| Localization | RAP60 | RAP140 | RAP220 | RAP300 | RAP380 | RAP460 | RAP540 | RAP620 | RAP700 | HU80 | HU120 | HU160 | rpd3Δ_1 | rpd3Δ_2 | rpd3Δ_3 |
|---|---|---|---|---|---|---|---|---|---|---|---|---|---|---|---|
| Cortical Patches | 0 | 0 | 0 | 0 | – | 0 | 0 | 0 | 0 | 0 | 0 | 0 | 0 | 0 | 0 |
| Bud | 0 | 0 | 0 | 0 | – | 0 | 0 | 0 | 0 | 0 | 0 | 0 | 0 | 0 | 0 |
| Bud Neck | 0 | 0 | 0 | 0 | – | 0 | 0 | 0 | 0 | 0 | 0 | 0 | 0 | 0 | 0 |
| Bud Site | 0 | 0 | 0 | 0 | – | 0 | 0 | 0 | 0 | 0 | 0 | 0 | 0 | 0 | 0 |
| Cell Periphery | 0 | 0 | 0 | 0 | – | 0 | 0 | 0 | 0 | 0 | 0 | 0 | 0 | 0 | 0 |
| Cytoplasm | -0.5 | 0.6 | 1.0 | 0.9 | – | 0.7 | 0 | 0.6 | 0 | 0 | 2.0 | 3.6 | -0.2 | -0.4 | 1.4 |
| Endoplasmic Reticulum | 0 | 0 | 0 | 0 | – | 0 | 0 | 0 | 0 | 0 | 0 | 0 | 0 | 0 | 0 |
| Endosome | 0 | 0 | 0 | 0 | – | 0 | 0 | 0 | 0 | 0 | 0 | 0 | 0 | 0 | 0 |
| Golgi | 0 | 0 | 0 | 0 | – | 0 | 0 | 0 | 0 | 0 | 0 | 0 | 3.4 | 3.8 | 2.9 |
| Mitochondria | 0 | 0 | 3.5 | 0 | – | 3.4 | 2.9 | 4.1 | 3.5 | 0 | 0 | 0 | 0 | 0 | 0 |
| Nucleus | 0.4 | -3.1 | -4.5 | -3.7 | – | -3.8 | -4.6 | -5.9 | -5.6 | -0.4 | -2.6 | -5.2 | -5.3 | -5.7 | -7.8 |
| Nuclear Periphery | 0 | 0 | 0 | 0 | – | 0 | 0 | 0 | 0 | 0 | 0 | 0 | 0 | 0 | 0 |
| Nucleolus | 0 | 0 | 2.0 | 0 | – | 1.6 | 2.4 | 3.4 | 3.4 | 1.5 | 0 | 0.8 | 0 | 0 | 0 |
| Peroxisomes | 0 | 0 | 0 | 0 | – | 0 | 0 | 0 | 0 | 0 | 0 | 0 | 0 | 0 | 0 |
| SpindlePole | 0 | 0 | 0 | 0 | – | 0 | 0 | 0 | 0 | 0 | 0 | 0 | 0 | 0 | 0 |
| Vacuole | -0.5 | 2.8 | 3.0 | 3.2 | – | 2.5 | 2.8 | 3.0 | 3.4 | -0.2 | 0.9 | 2.1 | 4.8 | 5.2 | 7.0 |
External localization resources
Images






























Protein Concentration and Protein Localization Data
| R1 | R2 | R3 | ||||||||||||||||
|---|---|---|---|---|---|---|---|---|---|---|---|---|---|---|---|---|---|---|
| G1 Pre-START | G1 Post-START | S/G2 | Metaphase | Anaphase | Telophase | G1 Pre-START | G1 Post-START | S/G2 | Metaphase | Anaphase | Telophase | G1 Pre-START | G1 Post-START | S/G2 | Metaphase | Anaphase | Telophase | |
| Concentration | 3.5907 | 4.0182 | 2.9824 | 2.8019 | 2.4393 | 2.9634 | 5.3508 | 6.0434 | 5.105 | 4.4721 | 5.0087 | 5.2993 | 6.3035 | 7.6322 | 6.4081 | 6.6508 | 6.1973 | 6.2411 |
| Actin | 0.0339 | 0 | 0.0065 | 0 | 0.0495 | 0.001 | 0.0388 | 0.0007 | 0.0133 | 0.0066 | 0.0072 | 0.0023 | 0.0028 | 0.0025 | 0.0108 | 0.0115 | 0 | 0.0004 |
| Bud | 0.0009 | 0 | 0.0001 | 0 | 0.0006 | 0 | 0.0015 | 0.0001 | 0.001 | 0.0001 | 0.0008 | 0.0001 | 0.0007 | 0.0001 | 0.0003 | 0.0003 | 0 | 0.0002 |
| Bud Neck | 0.0067 | 0 | 0.0004 | 0 | 0.0011 | 0.0004 | 0.0052 | 0.0003 | 0.0022 | 0.0003 | 0.0004 | 0.0007 | 0.0018 | 0.0001 | 0.0004 | 0.0001 | 0.0001 | 0.0006 |
| Bud Periphery | 0.0023 | 0 | 0.0002 | 0 | 0.0007 | 0.0001 | 0.0037 | 0.0001 | 0.0029 | 0.0001 | 0.0015 | 0.0002 | 0.0023 | 0.0001 | 0.0008 | 0.0005 | 0 | 0.0003 |
| Bud Site | 0.0049 | 0 | 0.0003 | 0 | 0.0101 | 0.0001 | 0.0083 | 0.0012 | 0.0108 | 0.0003 | 0.0048 | 0.0002 | 0.0025 | 0.001 | 0.0058 | 0.0003 | 0 | 0.0005 |
| Cell Periphery | 0.0014 | 0 | 0.0001 | 0 | 0.0001 | 0 | 0.0019 | 0 | 0.0004 | 0 | 0.0003 | 0.0001 | 0.0013 | 0.0001 | 0.0003 | 0 | 0 | 0.0001 |
| Cytoplasm | 0.0069 | 0 | 0.0006 | 0 | 0.0003 | 0.0006 | 0.0028 | 0.0008 | 0.0022 | 0.0018 | 0.0011 | 0.0003 | 0.0043 | 0.007 | 0.0033 | 0 | 0 | 0.0004 |
| Cytoplasmic Foci | 0.01 | 0 | 0.0017 | 0 | 0.0146 | 0.0011 | 0.021 | 0.0021 | 0.0078 | 0.0116 | 0.007 | 0.0006 | 0.0155 | 0.005 | 0.0127 | 0.0015 | 0 | 0.0006 |
| Eisosomes | 0.0009 | 0 | 0.0001 | 0 | 0.0002 | 0 | 0.0008 | 0 | 0.0001 | 0 | 0.0002 | 0 | 0.0001 | 0 | 0.0002 | 0.0001 | 0 | 0 |
| Endoplasmic Reticulum | 0.0053 | 0 | 0.0008 | 0 | 0.0008 | 0.0008 | 0.0045 | 0.0001 | 0.003 | 0.0016 | 0.0046 | 0.001 | 0.0033 | 0.0003 | 0.0008 | 0 | 0 | 0.0002 |
| Endosome | 0.0211 | 0 | 0.0095 | 0 | 0.0095 | 0.0054 | 0.0256 | 0.0028 | 0.0098 | 0.0087 | 0.042 | 0.0041 | 0.0107 | 0.0013 | 0.002 | 0.0015 | 0 | 0.0031 |
| Golgi | 0.0063 | 0 | 0.0044 | 0 | 0.0142 | 0.0018 | 0.0141 | 0.0015 | 0.0037 | 0.0025 | 0.0184 | 0.003 | 0.0038 | 0.0018 | 0.0012 | 0.003 | 0 | 0.0004 |
| Lipid Particles | 0.0141 | 0 | 0.0039 | 0 | 0.0127 | 0.0017 | 0.0278 | 0.0018 | 0.0082 | 0.01 | 0.0291 | 0.0044 | 0.0109 | 0.0003 | 0.0025 | 0.0008 | 0 | 0.0008 |
| Mitochondria | 0.0078 | 0 | 0.0057 | 0 | 0.003 | 0.0021 | 0.0398 | 0.0005 | 0.007 | 0.0006 | 0.0908 | 0.0021 | 0.0134 | 0.0004 | 0.0087 | 0.047 | 0.0001 | 0.0076 |
| None | 0.0039 | 0 | 0.0009 | 0 | 0.0003 | 0.0007 | 0.006 | 0.0002 | 0.0008 | 0.0016 | 0.0015 | 0.0001 | 0.0013 | 0 | 0.0073 | 0.0001 | 0 | 0.0001 |
| Nuclear Periphery | 0.0269 | 0.0009 | 0.0091 | 0.0003 | 0.0009 | 0.0144 | 0.0268 | 0.0021 | 0.0027 | 0.0049 | 0.0199 | 0.0044 | 0.0404 | 0.0015 | 0.007 | 0.0001 | 0.0004 | 0.001 |
| Nucleolus | 0.0118 | 0.0039 | 0.0051 | 0.0024 | 0.0296 | 0.0161 | 0.0113 | 0.0055 | 0.0075 | 0.0049 | 0.0119 | 0.011 | 0.0259 | 0.0038 | 0.0036 | 0.0014 | 0.0258 | 0.0129 |
| Nucleus | 0.8067 | 0.9947 | 0.946 | 0.9972 | 0.8414 | 0.9512 | 0.7343 | 0.9759 | 0.9 | 0.9272 | 0.7416 | 0.9631 | 0.8236 | 0.9616 | 0.9249 | 0.9216 | 0.9731 | 0.9526 |
| Peroxisomes | 0.0076 | 0 | 0.0007 | 0 | 0.0069 | 0.0002 | 0.0101 | 0.0005 | 0.0082 | 0.0015 | 0.004 | 0.0002 | 0.0098 | 0.0051 | 0.0027 | 0.0101 | 0 | 0.0005 |
| Punctate Nuclear | 0.0136 | 0.0003 | 0.0018 | 0 | 0.002 | 0.0014 | 0.0062 | 0.0035 | 0.0033 | 0.0153 | 0.0028 | 0.001 | 0.0161 | 0.0009 | 0.0035 | 0.0001 | 0.0002 | 0.0112 |
| Vacuole | 0.0044 | 0 | 0.0011 | 0 | 0.0011 | 0.0003 | 0.0057 | 0.0002 | 0.0036 | 0.0002 | 0.0056 | 0.0005 | 0.006 | 0.0063 | 0.0008 | 0.0001 | 0 | 0.0053 |
| Vacuole Periphery | 0.0027 | 0 | 0.0009 | 0 | 0.0003 | 0.0006 | 0.0041 | 0.0001 | 0.0017 | 0.0002 | 0.0043 | 0.0005 | 0.0036 | 0.0008 | 0.0004 | 0.0001 | 0 | 0.0012 |
Sequencing Data
| R1 | R2 | |||||||||
|---|---|---|---|---|---|---|---|---|---|---|
| G1 Post-START | S/G2 | Metaphase | Anaphase | Telophase | G1 Post-START | S/G2 | Metaphase | Anaphase | Telophase | |
| Gene Expression | 70.1587 | 87.4245 | 63.4625 | 58.9248 | 79.9379 | 80.744 | 58.1292 | 75.2241 | 72.4397 | 69.1743 |
| Translational Efficiency | 1.7682 | 1.6159 | 1.8831 | 2.5707 | 1.5853 | 1.6079 | 2.3315 | 2.0777 | 1.8194 | 1.8027 |
Hit Data
| Dataset | Hit |
|---|---|
| Protein Concentration | ✔ |
| Protein Localization | ✘ |
| Gene Expression | ✘ |
| Translational Efficiency | ✘ |
Endocytosis
| Temp | Actin Patch (Sac6-tdTomato) | Cortical Patch (Sla1-GFP) | Late Endosome (Snf7-GFP) | Vacuole (Vph1-GFP) |
|---|---|---|---|---|
| 37℃ | ||||
| RT |
Cell Cycle Omics
CYCLoPs (Rad6-GFP)
| Gene / Allele | Actin Patch (Sac6-tdTomato) | Cortical Patch (Sla1-GFP) | Late Endosome (Snf7-GFP) | Vacuole (Sac6-tdTomato) |
|---|
| Gene | Images |
|---|
| Gene | Images |
|---|
Images are not yet available
Images are not yet available